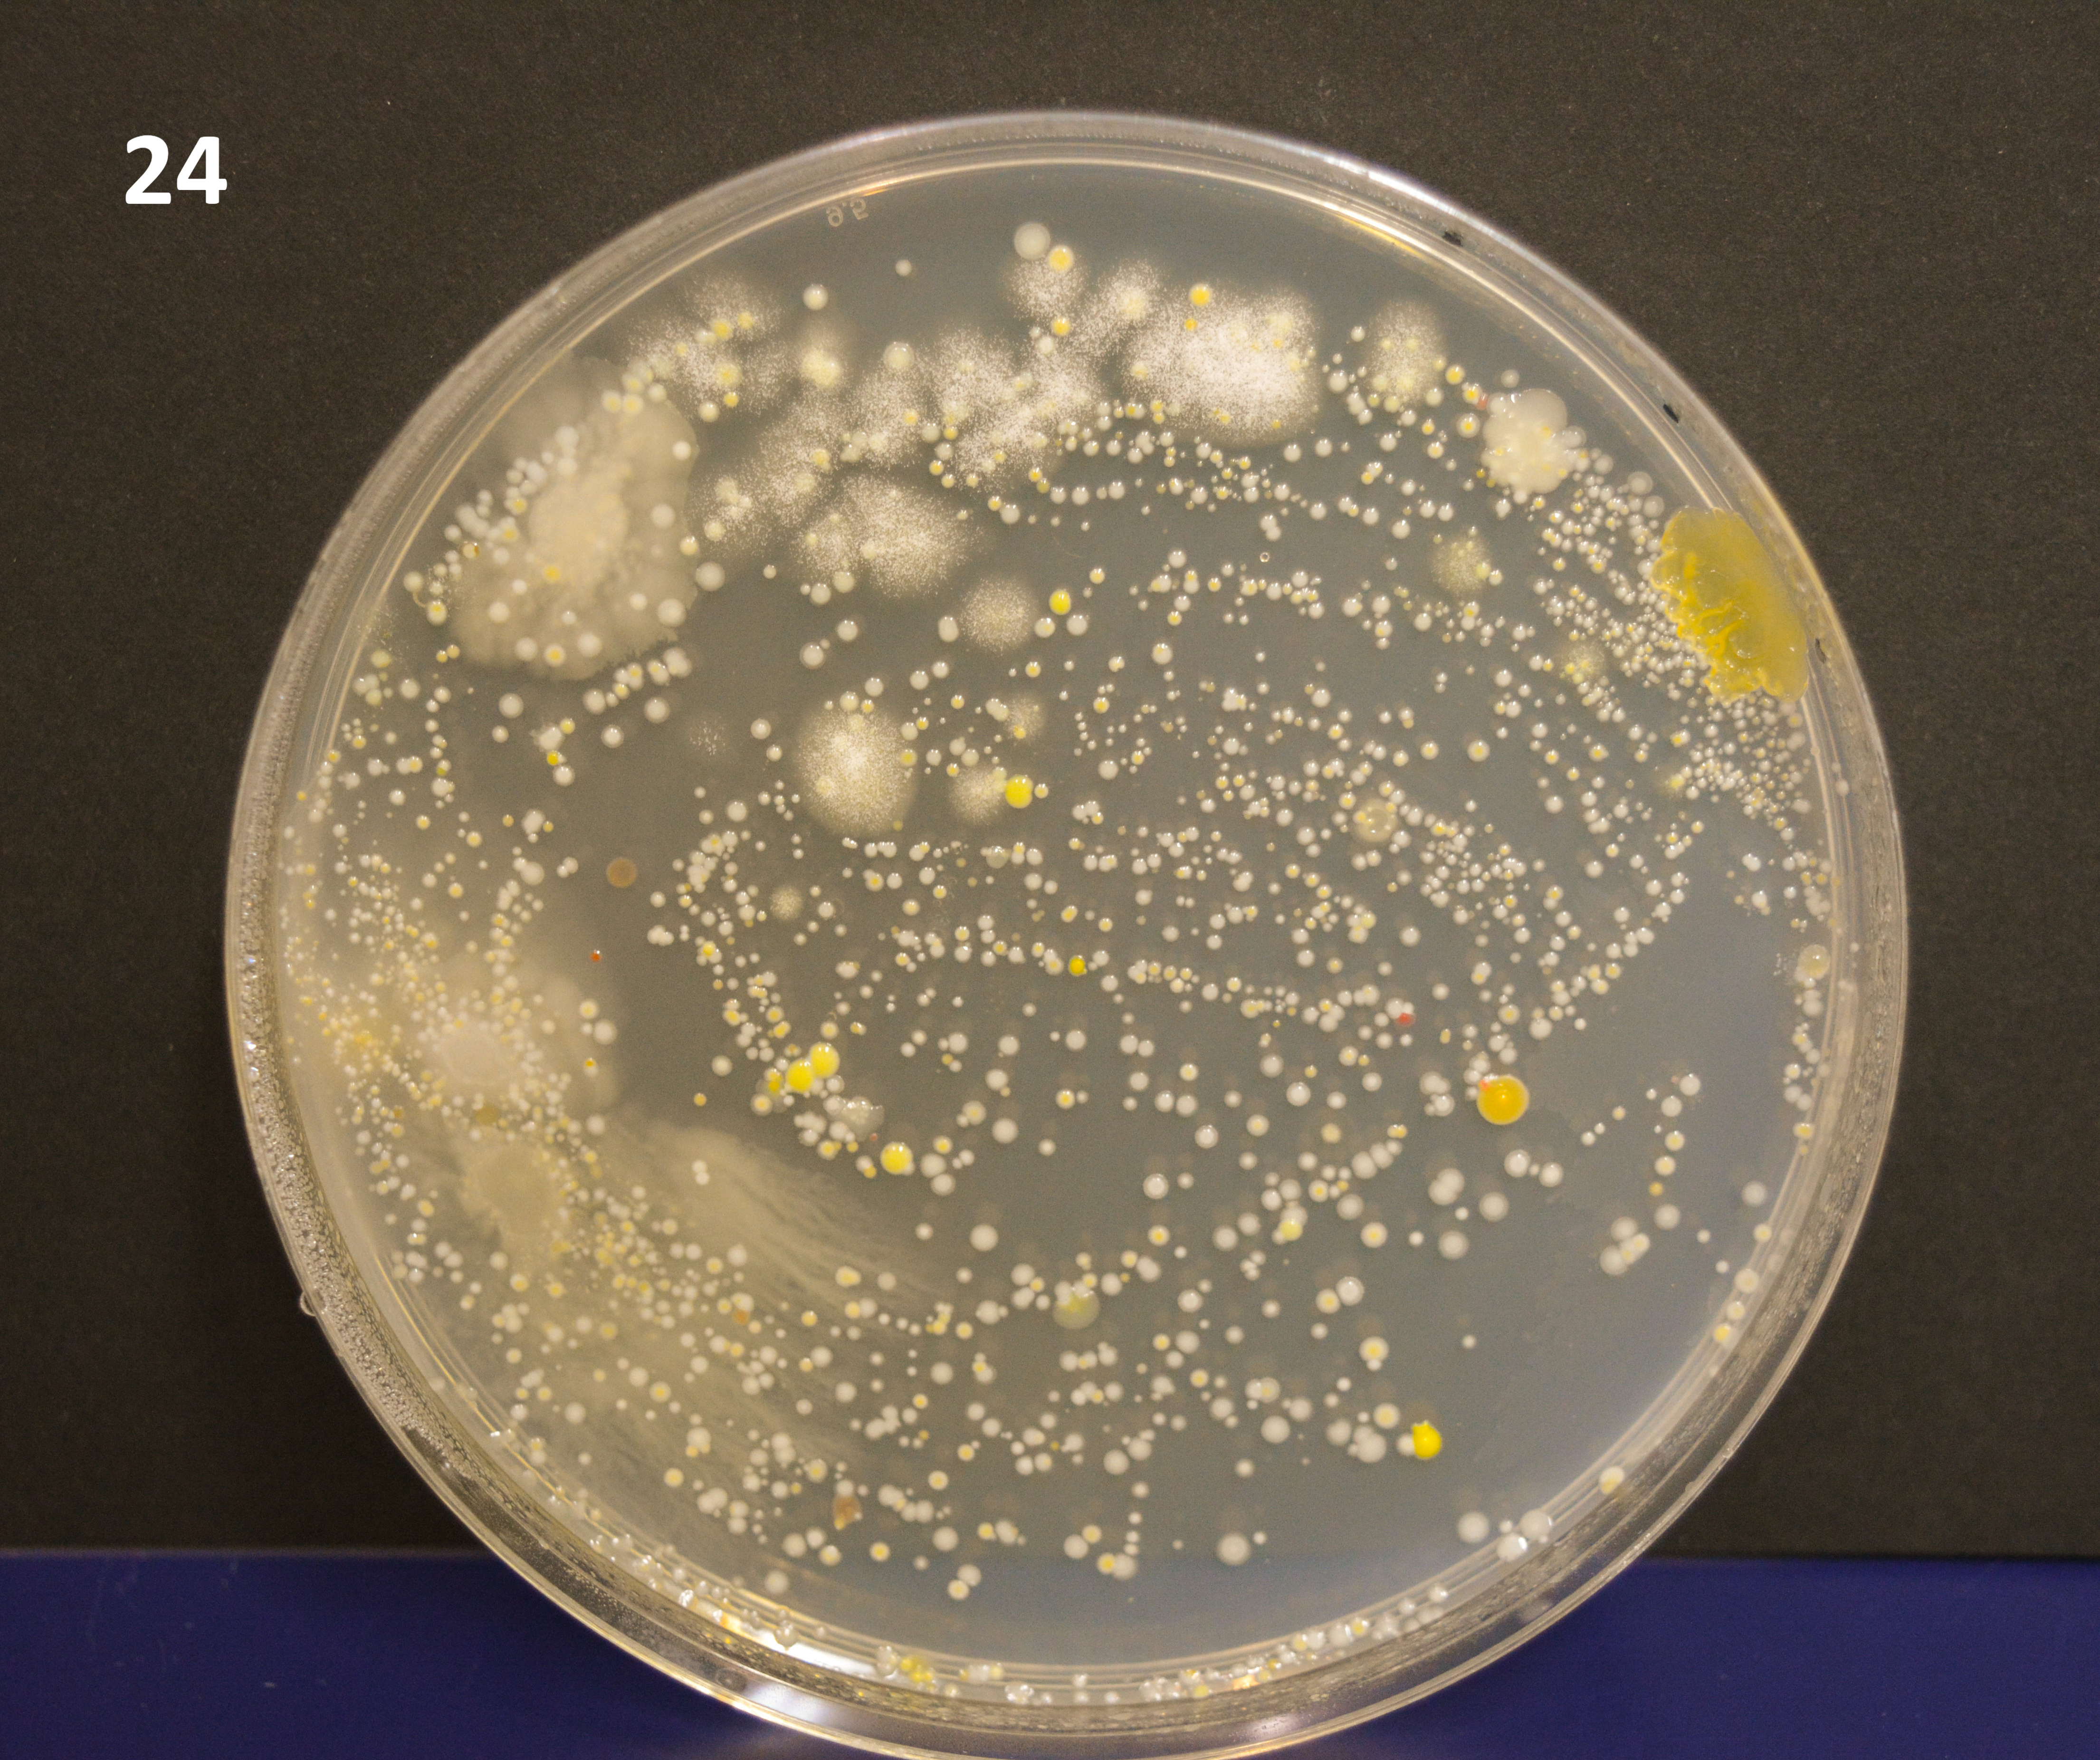

Les persones que van fer els tallers de salut a Villar del Arzobispo van poder passar el dit de la mà a una placa de cultius i així fer un cultiu dels microorganismes que tenim a les mans. En uns dies d'incubació a una estufa de 37 ºC han crescut els següents microorganismes:
(recorda el teu número per identificar la teua placa)
Images: